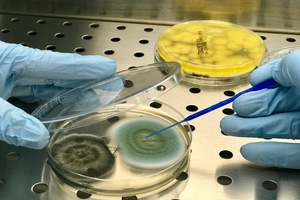

Corona und die Raumluft
Es dürfte schwer sein, aus der Corona-Pandemie etwas Positives mitzunehmen. Was wir jedoch positiv bewerten können, ist die Tatsache, dass die Raumluft bzw. auch Raumlufttechnischen Anlagen (RLT-Anlagen) nun endlich die Aufmerksamkeit bekommen, die ihnen bereits in den letzten Jahrzehnten hätte zukommen müssen. Quasi über Nacht wurde klar, dass die Raumluft eine wichtige Rolle für unsere Gesundheit spielt.
Jedoch hat der aktuelle Hype um die Raumluft auch einige fragwürdige Marktteilnehmer hervorgebracht, die mit allerlei Luftfiltern und „Luftwäschern“ ihr Glück versuchen. Dass diese Geräte keinesfalls die alleinige Lösung sind, sondern nur unterstützend hinzugezogen werden sollten, haben verschiedene Expertengremien (u.a. das Umweltbundesamt, die Deutsche Gesetzliche Unfallversicherung und die Deutsche Gesellschaft für Krankenhaushygiene) angegeben [1,2,3].
Doch legen wir den Fokus zunächst auf die ganzheitliche Betrachtung Raumlufttechnischer Anlagen, und hier im Wesentlichen auf die folgenden...